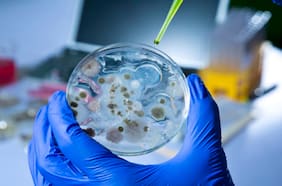
Identifican 70 enzimas capaces de devorar los residuos de la industria textil

Poliéster
25 SEPTIEMBRE
03 JUNIO
No es como la de los superhéroes, sino una ajustada prenda que va debajo de la ropa y cuya tecnología ayuda a mantener el calor corporal. Andinistas y expertos en outdoor comentan cuáles son los mejores materiales y modelos que existen.
Primera capa: ¿por qué es la mejor superprenda para soportar el frío?
08 FEBRERO
Lo más leído
1.
3.
4.
Plan digital + LT Beneficios por 3 meses
Navidad con buen periodismo, descuentos y experiencias🎄$3.990/mes SUSCRÍBETE